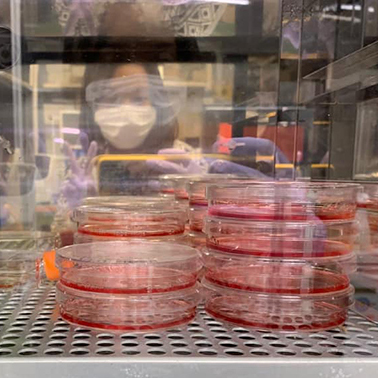
スラチャダ・チュアイチョブ

地域を歩いて語り合って見つける
人にも自然にも望ましい発展への道

2025年春号
巻頭特集
経済発展が目覚ましく、急速に存在感を高めるASEAN諸国。活気を帯びる一方で、発展の副産物として、自然破壊や社会経済格差の拡大などの様々な課題も生まれている。世界に先駆けて東南アジアでのフィールド研究に注力してきた京都大学。近年、これまでに蓄積した知見、築いてきた強固な関係を礎に、ASEAN諸国と力を合わせた課題解決への挑戦が始まっている。







地域の平和と安定に取り組むことを目的に1967年に設立されたASEAN。設立当時の加盟国はタイ、インドネシア、シンガポール、フィリピン、マレーシアの5か国。その後、ブルネイ、ベトナム、ラオス、ミャンマー、カンボジアが順次加盟し、現在は10か国で構成される。2015年には、加盟国を一つの経済圏とみなし、物品やサービス、投資などの自由化を図る経済共同体の枠組みを発足。
![]()
クリックで詳細が表示されます


|
ASEAN拠点を中核として、
東南アジア諸国との研究・教育における協力は ますます強固になっています |
ダブル・ディグリープログラム 京都大学の研究科等と海外の大学とが協定を結び、双方の卒業要件を満たした学生にそれぞれ学位を授与する制度。 |
|
|---|---|---|
| On-site Laboratory 海外の大学や研究機関と共同で設置する現地運営型研究室。ASEAN地域では、タイに2か所、シンガポールに1か所のラボが設置されている。 |
地域同窓会(海外) 京都大学への留学生、研究者が帰国後、母国で組織する同窓会や、日本人駐在員が立ち上げた同窓会。 各同窓会についてはこちらから |
|
| 日ASEAN統合基金(JAIF)プロジェクト 2015年から日ASEAN科学技術イノベーション共同研究拠点(JASTIP)を通じて、地球規模課題や地域共通課題の解決に取り組むプラットフォームを形成してきた。2025年からは、同プロジェクトへ継承していく。 |
MOU(学術交流協定)の締結 各国の主要大学・機関と学術交流協定を締結し、世界的な研究交流を推進している。 大学間学術交流協定締結状況はこちらから |
|
京都大学動画ポータルサイト「KyotoU Channel」にて、ASEAN地域での多様な研究や教育について紹介しています。
⇾ 特集ページはこちらから
※ 写真をクリックするとそれぞれのインタビューに移動します。

地域計画学は、地域の持続可能な発展のあり方を追求する学問です。私たちの研究室はそこに「資源」という視点を加え、自然や人、文化、歴史などの地域資源を活用した発展を探っています。肝に銘じていることは「地域計画学に教科書はない」ということ。訪ねる地域ごとに、地形も暮らす人も、重ねてきた歴史や文化も違う。地域が違えば当然、地域計画も変わります。
研究フィールドであるベトナムやインドネシアなどの東南アジア各国の行政は、貧困問題の緩和などを目的に様々な政策を推し進めています。でも、現地のニーズにそぐわず定着・持続しないなどの事例がよくみられます。プランテーションも最初は利益になるのですが、植林した木材や商品作物の市場価格が下がり、以前よりも生活が悪くなる事例もありました。経済的な豊かさと、破綻のない地域計画を両立するには、地域の特徴を知り、現地のニーズに即した計画立案が欠かせません。
私たちの研究の核は地域住民への聞き取り調査。水源はどこか、どこにどんな植物が生えているのか、困っていることはなにか。情報を聞き出すには、誠実に接することは基本中の基本。日本とは全く違う作法、文化、礼儀などがあり、すぐに本音は聞けません。日本人の感覚で先入観を持たないこと、地域の課題を「自分ごと」として考えることも大事です。現地の人々と信頼関係を築くには足繁く通っても数か月はかかります。そうしてはじめて「実は……」という話が聞ける。ですから、教科書の代わりに伝えるならば一言、「いい人であれ」(笑)。
インドネシアにて、コーヒープランテーションの作業の合間の食事の準備(2015年撮影)
この先、東南アジアは人口減少の局面に入ります。農村の人口が減り、そこに住む人々の生業が破綻する可能性があります。私たちの研究室の半数以上は東南アジアからの留学生で、帰国後は研究機関や行政で働く人も。日本はすでに農村の過疎化を経験している国なので、日本の経験は世界各地で活かせます。私たちにとっても、現地調査には現地との〈伝手〉が必須ですから、調査を手助けしてくれる卒業生の存在は心強いです。これからも京大が培ってきた東南アジアとの連携をより強固にしながら、いいサイクルを巡らせてゆきたいです。
さいぜん・いずる
京都大学大学院農学研究科博士後期課程修了。京都大学地球環境学堂准教授などを経て、2019年から現職。
2004年12月26日、インドネシア西部のスマトラ島沖でM9.1の地震が発生。震源地に近かった私の調査地であるアチェ州は大津波に襲われ、17万人が犠牲になりました。震災前はインドネシアからの独立を求める内戦が続き、外部との連絡はほぼ遮断されていました。災害を機に内戦は終結し、支援を目的に国内外の人たちがふたたび足を踏み入れるようになりました。
私も震災の2か月後、4年ぶりにアチェを訪ねました。災害直後ですから、現地の方は暮らしの立て直しに手一杯。「外国人研究者の私だからこそ」と使命感に駆られ、被災状況の記録と復興過程の定点観測を始めました。
暮らした場所は津波に流され、被災の痕跡は復興の過程で消えてしまう。アチェの人たちは、被災と復興によって、二度、景観の喪失を経験することになりました。それは、記憶の〈拠り所〉をなくすことと同義です。津波後に生まれた若い世代や移住者も増えるなかで、どうやって被災の経験と記憶を繋ぐのかは課題でした。
津波から20年の節目の2024年、スマートフォン・アプリ「アチェ津波メモリーグラフ」を公開しました。参照画像と同一構図での撮影を支援するカメラ・アプリ「メモリーグラフ」を活用したもので、利用者は半透明で表示された被災当時の写真を、現在の風景と重ねて撮影することができます。撮影写真はアプリ内に共有され、アプリを通して誰でも復興の過程を辿れるのです。

2005年2月撮影の参照写真

2024年12月の撮影写真
アプリで撮影した写真のコンテストも実施。約1,500枚もの応募がありました。語ることはもちろん、聞き出すことも難しかった被災時の経験。撮影会で、写真に記憶を喚起されて、自然と対話が生まれる瞬間に立ち会えたのは印象的でした。
大震災を何度も経験した日本では、防災・復興に関する制度や工学の進歩はめざましい。一方で被災後の心のケアは不十分で、孤立を深める人も多くいます。互いに声を掛け合いながら再建に取り組むインドネシアの社会に学ぶことは多いです。それぞれの強みを持ち寄って、優れた災害対応の仕組みづくりにも繋げたいです。
アチェでは今なお震災前の内戦の傷が残り続けています。20年の節目を迎え、「次の10年、私に何ができるのか」と常に問いかけながら、アチェを見つめ続けます。
にし・よしみ
東京大学大学院総合文化研究科博士課程修了。東京大学大学院「人間の安全保障」プログラム 助教、立教大学 助教、京都大学地域研究統合情報センター 准教授などを経て2017年から現職。

京大に留学中のVISTECの学生と。右端が堀毛教授
京都大学がタイのウィタヤシリメティー科学技術大学(VISTEC)にOn-site Laboratory(オンサイトラボラトリー)「スマート材料研究センター」を開設したのは2018年。当時所属していた高等研究院iCeMSの北川進拠点長(当時)から、「これからはますます東南アジアだ」とラボの主宰を任されました。On-site Laboratoryとは、海外の大学や研究機関等と共同で設置する現地運営型研究室のこと。理学研究科に異動した現在も、年に数回は一週間から10日間ほど滞在するほか、オンライン面談は毎週実施。燃料電池などへの応用を視野に、材料化学の基礎研究の指導にあたっています。
VISTECは、2015年にタイ石油公社が設立した大学院大学。2035年までに主要な世界大学ランキングで50位以内に入ることを目標に掲げ、タイの優秀な若者を集めています。バンコクから自動車で2時間以上離れたラヨーン県にあり、落雷やスコールで頻繁に停電するタフな環境ですが、研究設備は最先端。学生はとても真面目で研究意欲も高く、私も刺激を受けています。
コロナ禍で研究交流が困難な時期も経て、2025年には初の博士号取得者を送り出す予定です。ラボの運営が軌道に乗っていると言っていただけることもありますが、学生を預かる立場上、常に安全や予算確保など、危機感を持っています。現地と協力して進めるにあたり、「設置させていただいている」と常に感謝の気持ちを持つことが大切です。また、京大はどう貢献できるかをしっかりとアピールし、共同相手として選び続けてもらえるよう努力する必要があります。
交流を持続・発展させる鍵は、やはり「人」のつながり。私の研究室には、VISTECからの留学生が常時数名在籍し、日本人学生と切磋琢磨しています。このように京大との関わりで学位を取得した彼らが研究者として活躍すれば、進学・留学先として京大に魅力を感じる学生がさらに増え、研究力強化にも繋がります。一つのラボでできることは小さいかもしれませんが、一人でも多くの材料化学研究者の育成を通して、互いに高め合える道筋を見据えています。
 キャンパスの全景。タイ経済の重要戦略地域である東部経済回廊に位置する。近い将来には、キャンパスに隣接してシンクロトロン施設が建設される
キャンパスの全景。タイ経済の重要戦略地域である東部経済回廊に位置する。近い将来には、キャンパスに隣接してシンクロトロン施設が建設される
ほりけ・さとし
京都大学大学院工学研究科博士後期課程修了。京都大学高等研究院主任研究員などを経て、2023年から現職。

生まれ育ったタイで、バイオセンサーの研究をしていました。バイオセンサーとは、生物の生体反応を利用して様々な物質を検出・計測するシステムです。医療分野での応用が盛んで、がん薬物療法の副作用の特定などに活用されています。タイでは、バイオセンサー研究の多くが大学病院発。医療現場の課題を起点に研究が始まります。海外との共同研究も活発で、私が参加したプロジェクトを通じて、日本の研究機関である理化学研究所と繋がりができたことが契機となり来日しました。
2020年に東京大学にて先端材料科学の博士号を取得した後、京都大学工学研究科の研究室にポスドクとして赴任。がん微小環境の生体反応を模倣したバイオチップを研究しました。京大に来て驚いたのは、あらゆる分野の研究が揃っていること。分野をまたいだ議論から、研究が思いもしない方向に広がる刺激的な日々でした。
2023年からは、エネルギー理工学研究所で脱炭素社会の実現を目指す研究に励んでいます。医療分野から離れて、エネルギー分野への挑戦です。一見、かけ離れた分野ですが、細菌や酵素などの生物の力を応用する視点は共通。私のデザインした物質を使って、二酸化炭素を吸収したり、発生を抑えたり、エネルギー問題に貢献できる技術を開発したいと意欲に燃えています。
脱炭素社会の実現は全世界の課題です。日本やタイに限らず、全世界にインパクトを与える可能性を秘めています。研究・実験は失敗の連続ですが、それは後退ではなく、「どんな状態でも得られるものはある」というのが私の考え方。たとえ大失敗したとしても、ゆっくりでも必ず前に進んでいます。この先、ときには遠回りや寄り道することがあるかもしれませんが、研究者として描いた夢は忘れずに、スケールの大きな目標を掲げて研究を続けていきます。

スラチャダ・チュアイチョブ
プリンス・オブ・ソンクラー大学で修士課程を取得。東京大学大学院新領域創成科学研究科博士後期課程 修了。京都大学大学院工学研究科 ポスドクを経て、2023年から現職。
>> 京都大学ASEAN拠点
>> 地球環境学堂
>> 東南アジア地域研究研究所
>> 理学研究科
>> On-site Laboratory「スマート材料研究センター」
>> エネルギー理工学研究所